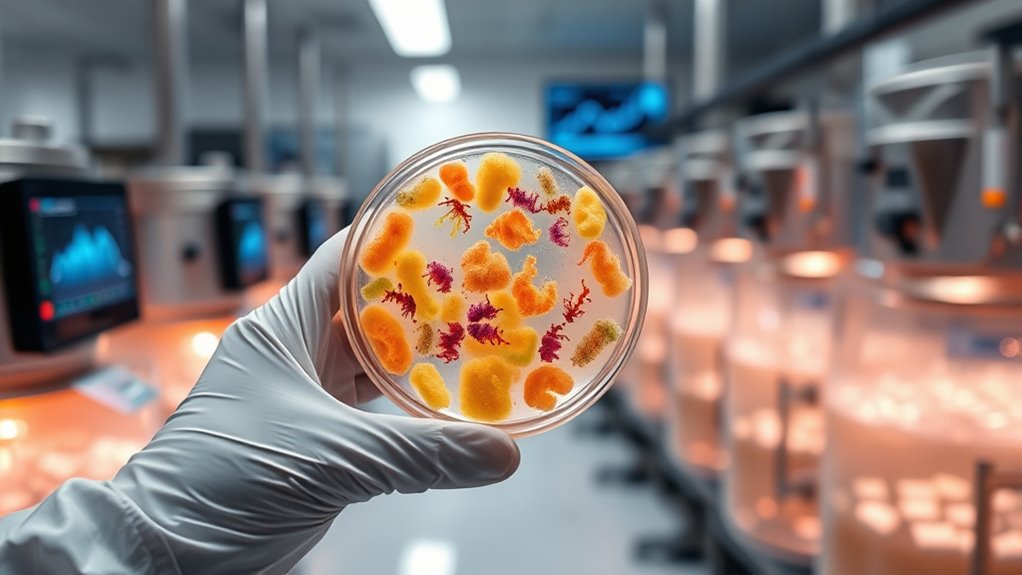
nutritional impacts of precision fermentation

Precision fermentation uses microbes like yeast or bacteria to produce animal-free proteins tailored to your nutritional needs. It can create foods with complete amino acid profiles, matching traditional animal products, while reducing saturated fats and adding beneficial nutrients. This innovative method offers a more sustainable way to get essential nutrients, with less environmental impact. As you explore further, you’ll discover how these products could transform nutrition and support healthier, eco-friendly diets.
Key Takeaways
- Precision fermentation produces animal-free proteins with complete amino acid profiles similar to traditional animal products.
- It allows customization of nutritional content, such as enhancing vitamins or reducing saturated fats.
- Microbial-derived foods can maintain essential nutrients, supporting balanced diets and dietary needs.
- The technology offers a sustainable way to produce nutrient-rich foods with a lower environmental impact.
- Ongoing research and regulation are vital to ensure the safety and long-term health implications of these novel proteins.

Have you ever wondered how scientists can produce animal-free proteins that taste and feel just like traditional meat or dairy? The answer lies in precision fermentation, a revolutionary process that harnesses microbial engineering to create tailored proteins. Instead of relying on raising animals, this technology manipulates microorganisms—like yeast, bacteria, or fungi—to produce specific compounds. By modifying their genetic makeup, scientists can direct these microbes to generate precise proteins that mimic those found in animal products. This approach not only reduces environmental impact but also offers unprecedented control over the final product’s characteristics.
Precision fermentation uses microbes to produce animal-free proteins with authentic taste and texture.
One of the key advantages of microbial engineering in precision fermentation is product customization. Researchers can fine-tune the microbes to produce proteins with particular textures, flavors, or nutritional profiles. For instance, if a company wants a plant-based cheese that melts just like dairy cheese, they can engineer microbes to produce the exact proteins responsible for that melting quality. Similarly, if a beverage needs a specific amino acid profile to boost nutritional value, scientists can modify the microbial pathways to enhance those nutrients. This level of customization allows brands to meet diverse consumer preferences and dietary needs more precisely than ever before.
From a nutritional standpoint, precision fermentation offers significant benefits. Since the microbes produce proteins identical or very similar to their animal-derived counterparts, the resulting products contain complete amino acid profiles and essential nutrients. This means you can enjoy plant-based or microbial-derived foods that match the nutritional quality of traditional animal products. Furthermore, because the process involves fewer steps and less resource use, it often results in products that are not only nutritious but also more sustainable. It’s possible to engineer these proteins to be lower in saturated fats or to include added vitamins, further enhancing their health benefits.
However, it’s important to recognize that this technology also raises questions about long-term health effects and regulatory oversight. While the nutritional content can be precisely controlled, ongoing research is needed to fully understand how these novel proteins interact with our bodies over time. As the technology advances, regulations will likely evolve to ensure safety and transparency, giving consumers confidence in these innovative foods.

Animal 100% Whey Protein Powder – Whey Blend for Pre Workout or Post Workout, Recovery, or an Anytime Low Sugar Protein Boost Meal Replacement with BCAA Branched Chain Amino Acids – Chocolate, 4 lb
20g of Protein per Scoop: Animal 100% Whey is pure protein fuel, formulated with a high quality whey…
As an affiliate, we earn on qualifying purchases.
As an affiliate, we earn on qualifying purchases.
Frequently Asked Questions
How Does Precision Fermentation Differ From Traditional Fermentation Methods?
You’ll find that precision fermentation differs from traditional methods by using targeted microbial processes to produce specific ingredients, often at a faster pace and with greater control. Unlike traditional fermentation, which relies on natural microbial activity, this technique allows you to precisely manipulate flavor development and nutritional content. This results in cleaner, more consistent products, giving you better control over the final taste and quality of the food or beverage.
Are Precision Fermentation Products Safe for All Dietary Restrictions?
Precision fermentation products are generally safe for most diets, but you should consider allergenicity concerns, as they can contain ingredients that trigger allergies. Cultural acceptance varies, and some people might be hesitant due to unfamiliarity. Always check product labels and consult with your healthcare provider if you have specific dietary restrictions or allergies. Being informed helps you make confident choices about incorporating these innovative foods into your diet.
What Environmental Benefits Does Precision Fermentation Offer?
You benefit from precision fermentation’s environmental advantages, as it promotes sustainable agriculture by using fewer resources and land. It also helps reduce greenhouse gases since it produces products more efficiently and with less emissions than traditional farming. By supporting this technology, you contribute to a healthier planet, cutting down on environmental impacts while still enjoying high-quality, nutritious foods. It’s a smart choice for both your health and the environment.
How Scalable Is Precision Fermentation Technology Globally?
You’re enthusiastic to know if precision fermentation can go global. While scalability challenges exist, advancements are accelerating, making worldwide implementation increasingly feasible. You might wonder if the technology can meet massive demand and adapt across diverse regions. The good news? With continuous innovation and investment, precision fermentation is set to expand, overcoming hurdles and revolutionizing sustainable food production on a truly global scale.
What Regulatory Challenges Exist for Commercializing Precision Fermentation Foods?
You’ll face regulatory approval hurdles and stringent labeling standards when commercializing precision fermentation foods. Authorities may require extensive safety assessments, which can slow down product launches. Additionally, labeling standards vary across regions, making it essential to clearly communicate the nature of these products to consumers. Managing these regulatory challenges demands careful planning and compliance to guarantee your precision fermentation foods can reach the market smoothly.

Madly Hadley Plant-Based Parmesan Cheese, 2 packs – 16oz | Original Vegan Cashew Parmesan Grated Topping for Pasta, Salad, Sauces | Dairy-Free, Gluten-Free, Non-GMO, Soy-Free, Keto-Friendly
HEALTHY CHEESE ALTERNATIVE: Enjoy the nutty, savory flavor of parmesan in a fully plant-based form. This dairy-free topping…
As an affiliate, we earn on qualifying purchases.
As an affiliate, we earn on qualifying purchases.
Conclusion
As you explore precision fermentation, think of it as revealing a hidden garden of nutritional treasures, cultivated with science and care. It’s like planting seeds of innovation that promise a future where food is both sustainable and nourishing. Embrace this technology as a guiding compass, steering us toward a healthier planet and brighter plates. In this journey, you hold the key to transforming what we eat into a vibrant, thriving ecosystem of possibilities.

SuperDFM – HoneyBee, Probiotic Supplement for Bees, 10 Applications
Establish Beneficial Microflora
As an affiliate, we earn on qualifying purchases.
As an affiliate, we earn on qualifying purchases.

Sustainable Protein Sources
As an affiliate, we earn on qualifying purchases.
As an affiliate, we earn on qualifying purchases.